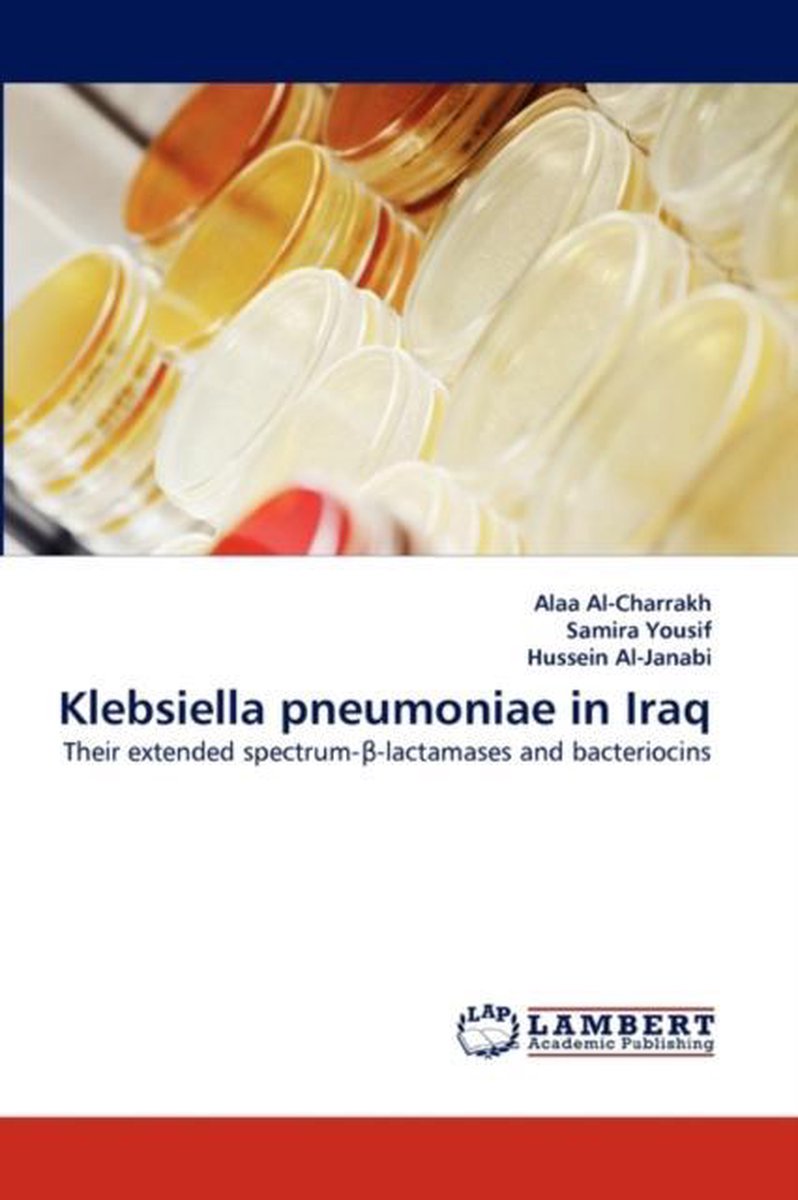

We hebben 3 boeken gevonden van de auteur Alaa Alcharrakh
Hieronder vindt u een lijst met alle gevonden boeken van de auteur Alaa Alcharrakh.
De meest gevonden boeken zijn Group C And Group G Streptococci, Klebsiella Pneumoniae In Iraq en Methicillin Resistant Staphylococcus Aureus.
De meest gevonden boeken zijn Group C And Group G Streptococci, Klebsiella Pneumoniae In Iraq en Methicillin Resistant Staphylococcus Aureus.
Sorteer op: